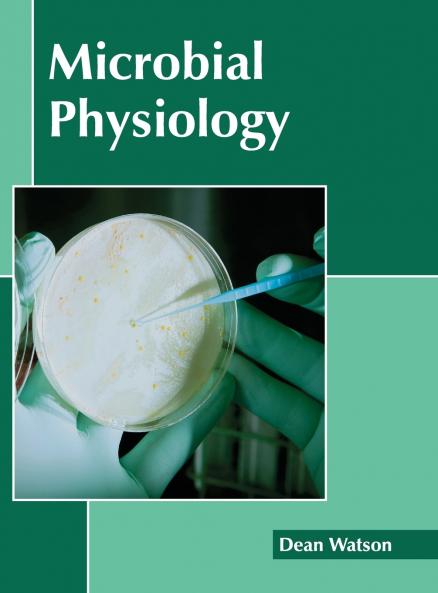
Microbial Physiology

English
Hardback
₹12688
₹14552
12.81% OFF
(All inclusive*)
Delivery Options
Please enter pincode to check delivery time.
*COD & Shipping Charges may apply on certain items.
Review final details at checkout.
Looking to place a bulk order? SUBMIT DETAILS
Delivery Options
Please enter pincode to check delivery time.
*COD & Shipping Charges may apply on certain items.
Review final details at checkout.
About The Book
Description
Author
This book unravels the recent studies in the field of microbial physiology. It also provides interesting topics for research which readers can take up. Microbial physiology refers to the biochemical examination of the microbial cell functions. It also includes an in-depth study of microbial metabolism microbial growth microbial cell structure etc. While understanding the long-term perspectives of these topics the book makes an effort in highlighting their impact as a modern tool for the growth of the discipline. It aims to shed light on some of the unexplored aspects and the recent researches in this area. Scientists and students actively engaged in the field of microbial physiology will find this book full of crucial and unexplored concepts.
Details
ISBN 13
9781632398093
Publication Date
-26-06-2017
Pages
-234
Weight
-714 grams
Dimensions
-216x280x14.29 mm